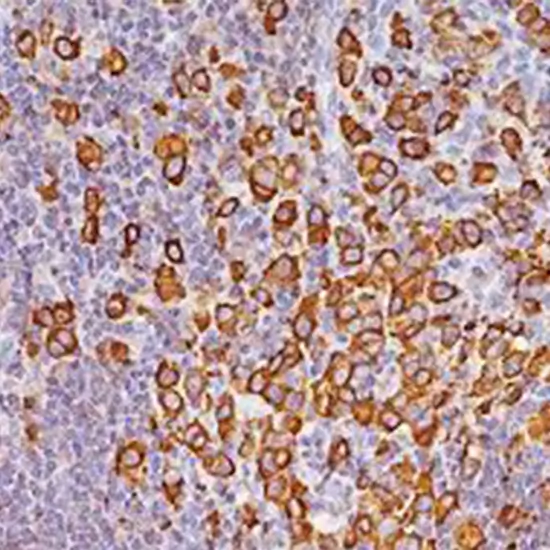

Book Immunohistochemistry Epithelial Membrane Antigen Appointment Online Near me at the best price in Delhi/NCR from Ganesh Diagnostic. NABL & NABH Accredited Diagnostic centre and Pathology lab in Delhi offering a wide range of Radiology & Pathology tests. Get Free Ambulance & Free Home Sample collection. 24X7 Hour Open. Call Now at 011-47-444-444 to Book your Immunohistochemistry Epithelial Membrane Antigen
The surface of numerous healthy classes of epithelium, like those in the pancreas, stomach, intestine, salivary gland, respiratory tract, urinary tract, and breast, comprises a class of HMW molecules that are prosperous in carbohydrates but inadequate in protein. This group of molecules is understood as epithelial membrane antigen (EMA), and it is an incompletely depicted antigen.
The membrane of secretory epithelia comprises epithelial membrane antigen (EMA). The antibody marks Reed-Sternberg cells in nodular lymphocyte predominance Hodgkin's lymphoma and neoplastic cells in a subset of anaplastic large cell lymphomas for the classification of hematolymphoid neoplasms.
IHC with interpretation for epithelial membrane antigen These CD markers are established on respective hematological cells. On unidentified cells, precise IHC markers can be applied individually or in classes, and the existence or scarcity of the antigen can help in describing the target cell.
Glycoproteins sheltered from human milk fat globule membranes, designated epithelial membrane antigen (EMA), have been noticed immunohistochemically in most nonneoplastic epithelia and are possibly a highly influential marker for selecting the epithelial disposition of neoplastic cells.
It serves as a target in immunohistochemistry where it is a common epithelial marker and expressed by many adenocarcinomas with a poor prognosis beyond that it is expressed by meningiomas, Paget disease, epithelioid sarcomas, and synovial sarcomas It also is sometimes seen within the cytoplasm of cells (e.g. perinuclear dot in ependymomas)
IHC manifestation for Ordinary tissues
Patient Preparation
Tissue or compartments.
Formalin fix and paraffin-embedded sample. Protection paraffin bloc and drops from disproportionate warmth. Transport tissue block or five unstained entirely prosecuted drops in a tissue carrier kit.
Chamber temperature or cooled. Export in a cooled receptacle during the summer months.
Samples proposed with non-representative tissue variety. Drained samples.
IHC Ordering and Submission Details: A submitted electronic proposal. If you do not have the electronic mandating capacity, use an ARUP IHC Stain Form with an ARUP customer numeral.
Ambient: unspecified; Chilled: unspecified; Frozen: Indecent
IHC
Inhibin antibody immunostaining
Inhibin IHC
Consideration Interval
This examination was formulated and its interpretation traits were specified by ARUP Labs. It has not been emptied or authorized by the US ie. This examination was conducted in a CLIA-certified lab and is planned for clinical objectives.
| Test Type | Immunohistochemistry Epithelial Membrane Antigen |
| Includes | Immunohistochemistry Epithelial Membrane Antigen Test (Oncology) |
| Preparation | |
| Reporting | Within 24 hours* |
| Test Price |
₹ 2250
|

Early check ups are always better than delayed ones. Safety, precaution & care is depicted from the several health checkups. Here, we present simple & comprehensive health packages for any kind of testing to ensure the early prescribed treatment to safeguard your health.